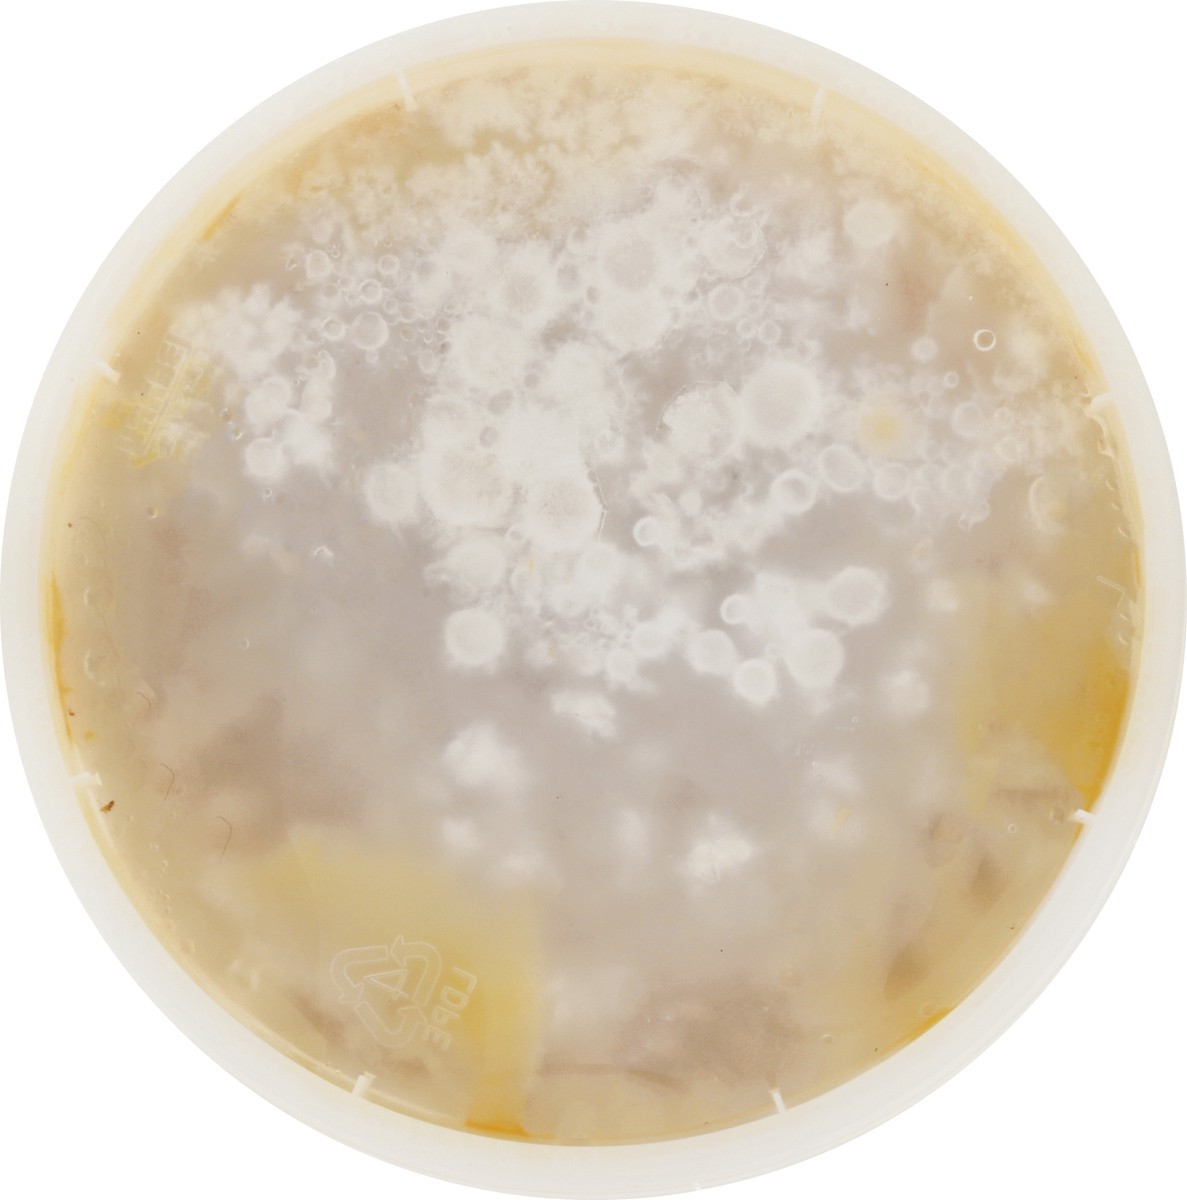
slide 3 of 9, Urban Ladle Butternut Squash Soup, 30 oz

Gluten free and vegan. Artisan soups. A bowl of creamy freshness. Velvety blend of butternut squash, slow-simmered fresh vegetable stock, almond milk, agave nectar, ginger, and finished with white pep…
Ingredients
Butternut Squash, Vegetable Stock (Water, Carrots, Celery, Thyme, Parsley, Salt, Peppercorn), Almond Milk (Almond, Cane Sugar, Sea Salt, Locust Bean Gum, Sunflower Lecithin, Gellan Gum), Agave Nectar,…